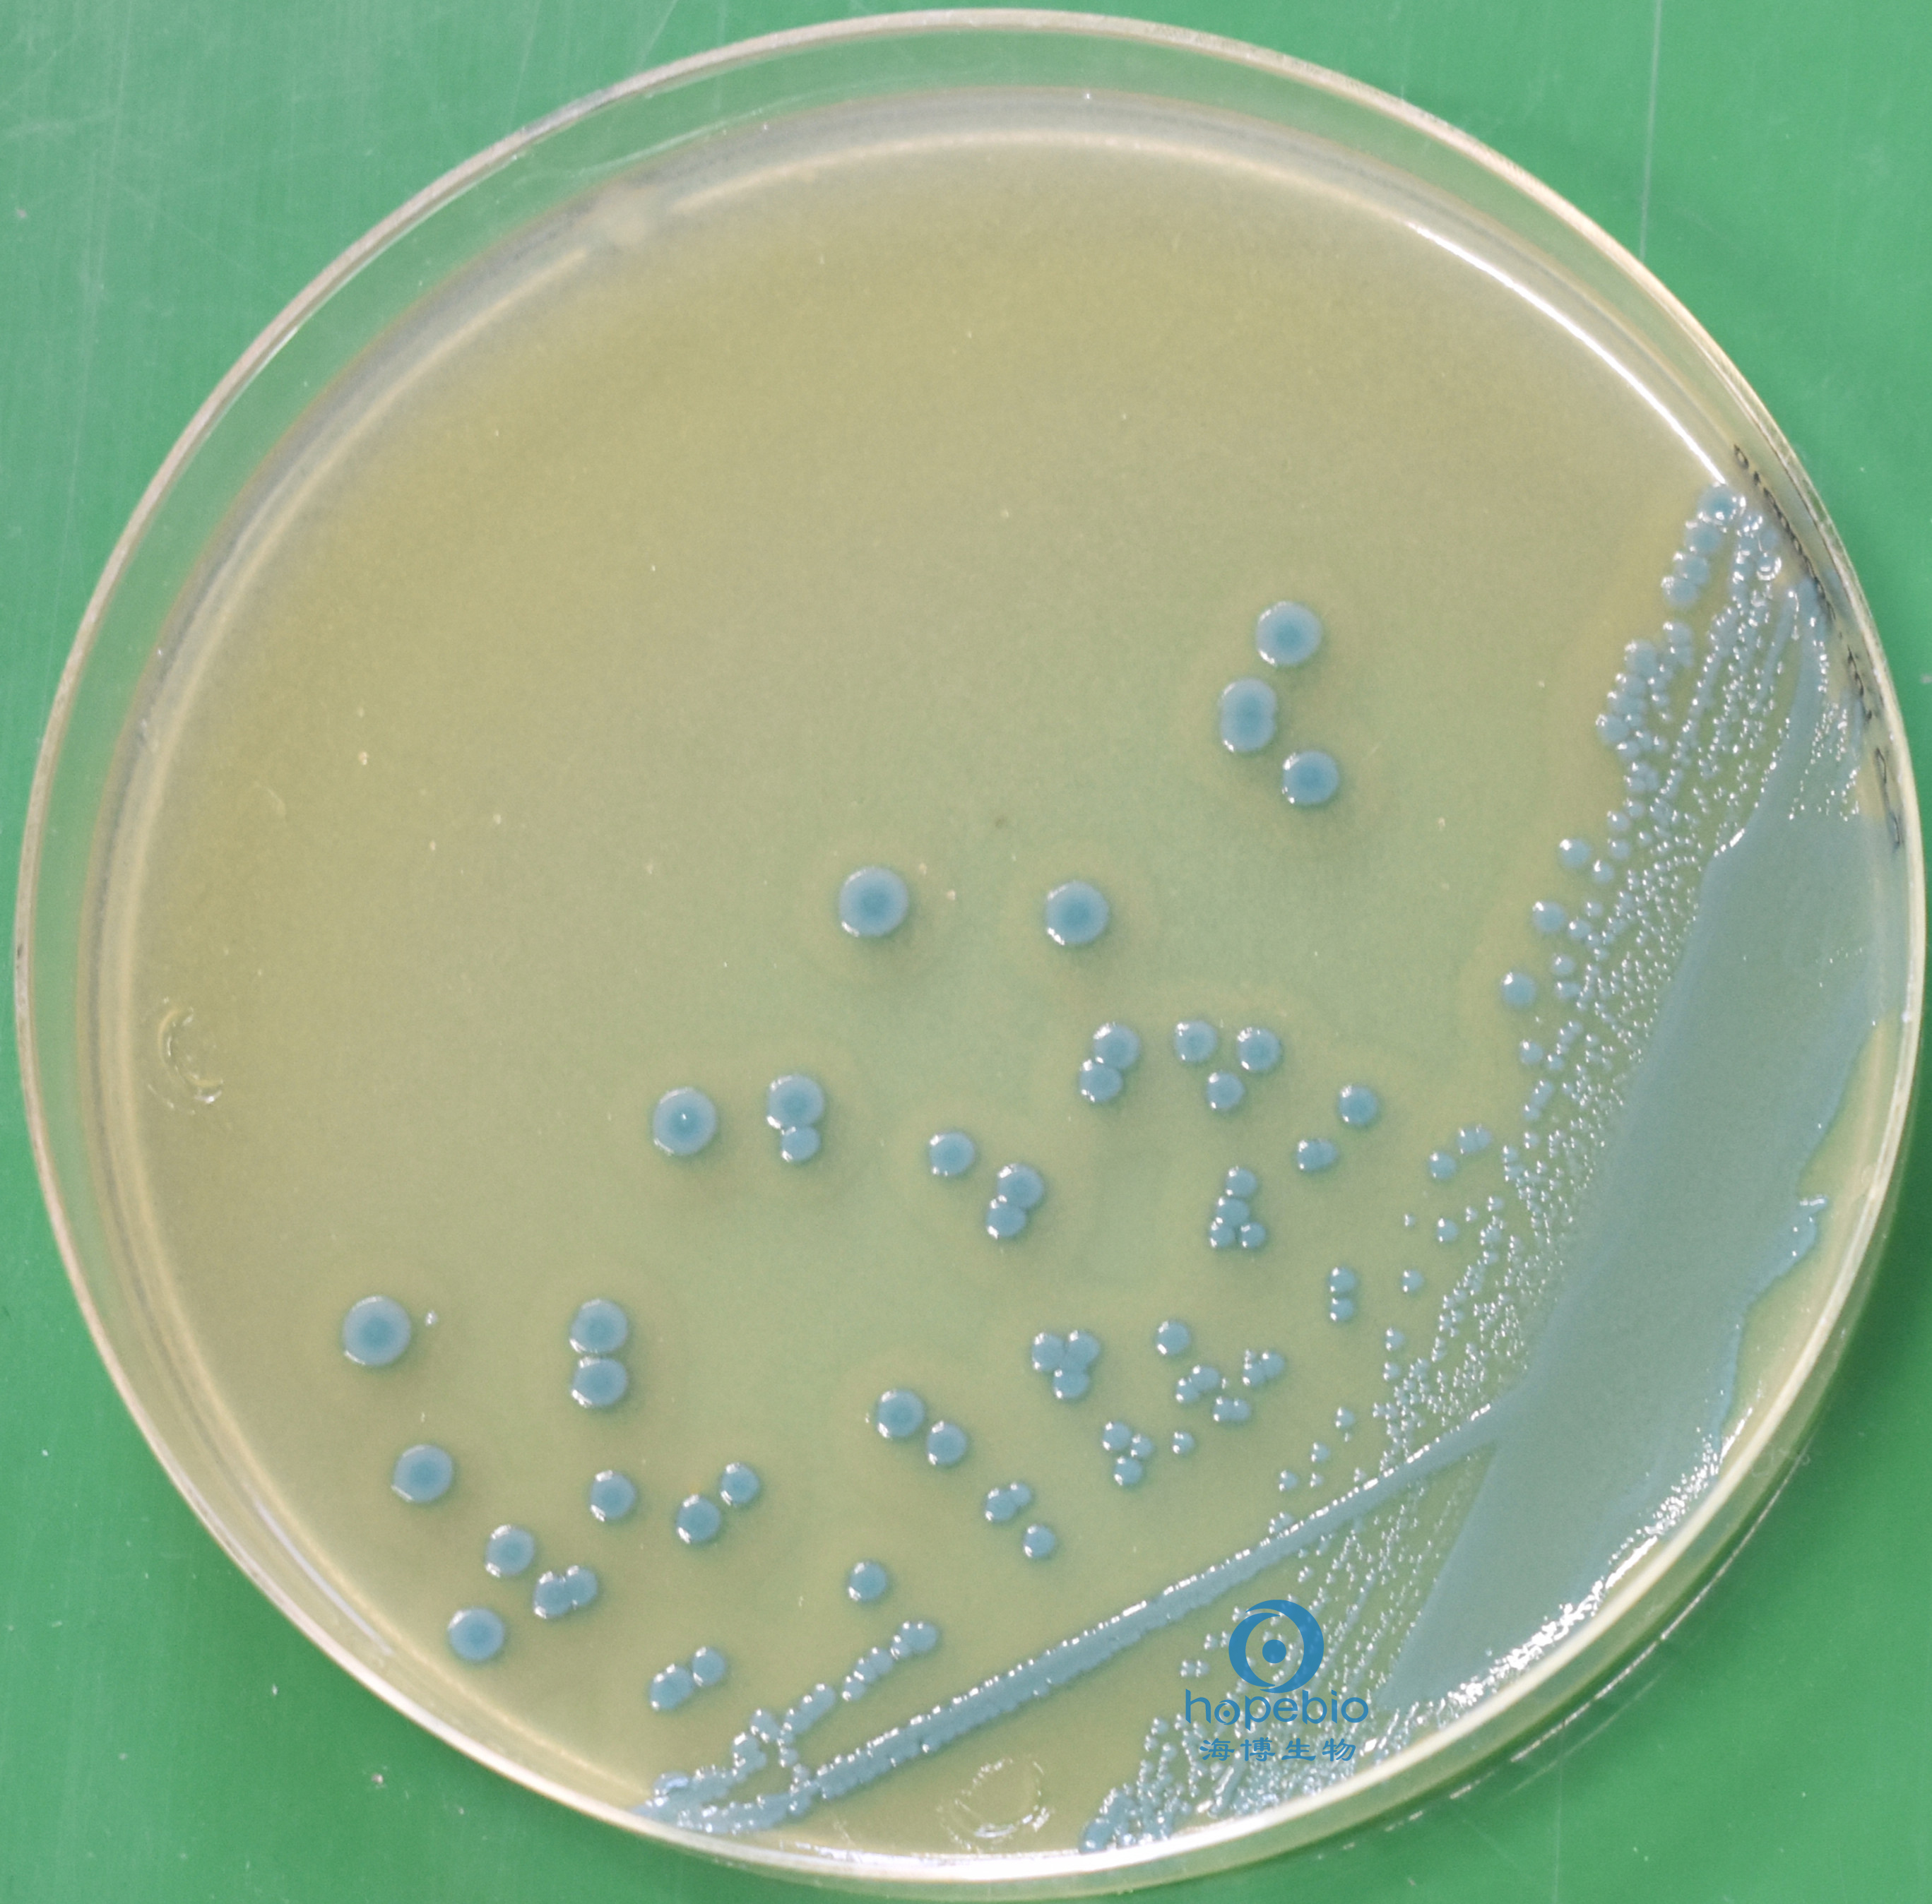
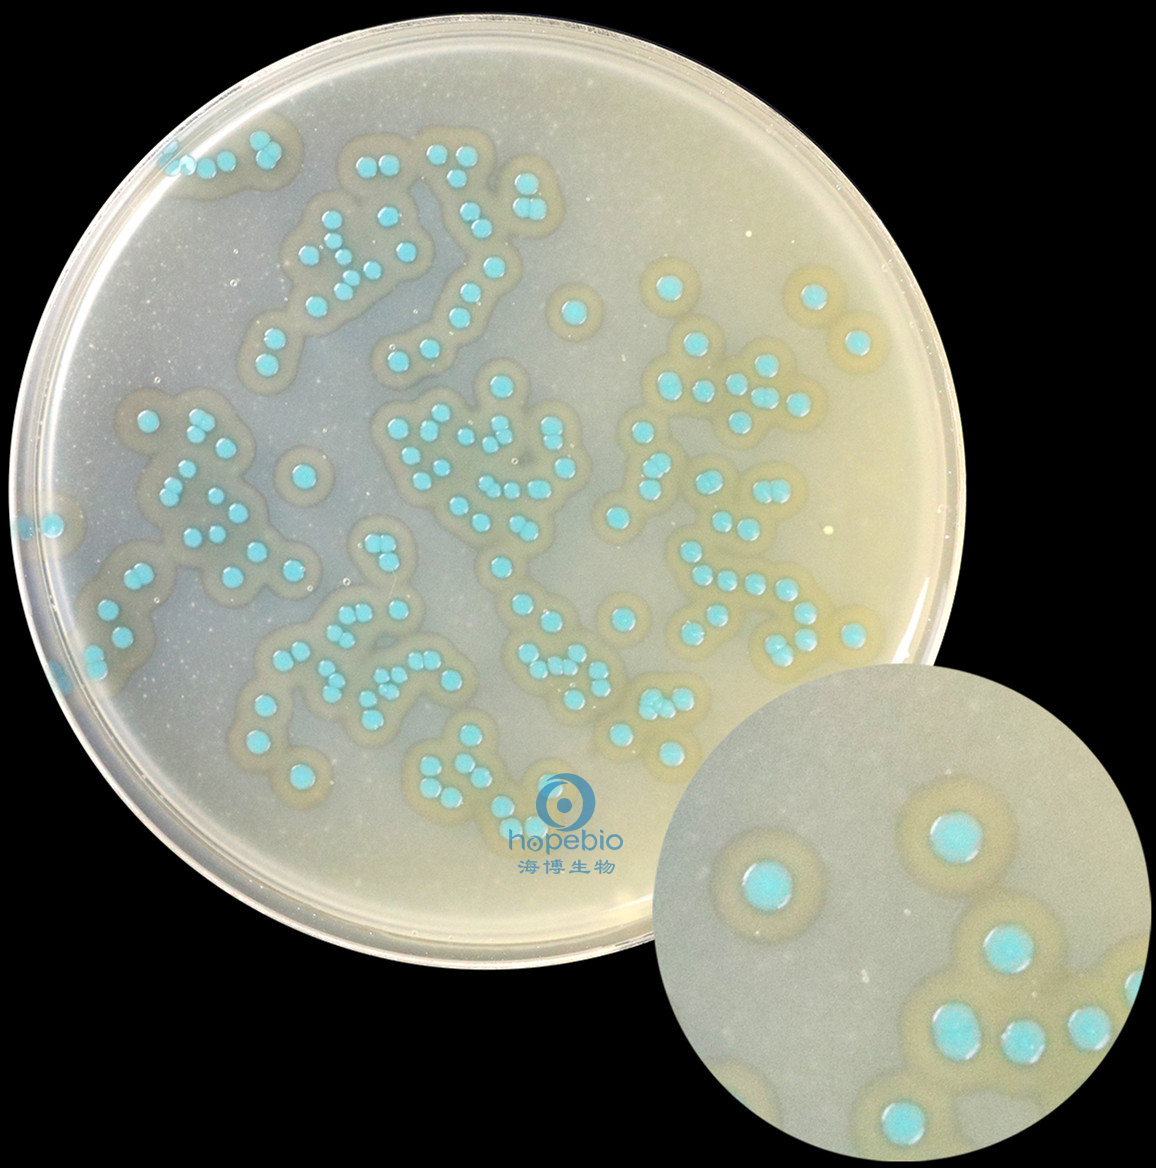

海博微信公众号
海博微信公众号
 海博天猫旗舰店
海博天猫旗舰店


 海博微信公众号
海博微信公众号
 海博天猫旗舰店
海博天猫旗舰店




一、参考标准
食品国标GB4789.30-2016《食品安全国家标准 食品微生物学检验 单核细胞增生李斯特氏菌检验》
二、检验流程
单增李斯特氏菌计数有两种方法:MPN法和平板计数法。
(一)MPN法

1、样品稀释均质
无菌操作称取样品25g(mL),放入盛有225mL LB1的无菌均质袋内(或均质杯)内,振荡混匀,制成1∶10的样品匀液。
用1mL 无菌吸管或微量移液器吸取1∶10样品匀液1mL,沿管壁缓慢注于盛有9mL缓冲蛋白胨水或无添加剂的LB肉汤的无菌试管中(注意吸管或吸头尖端不要触及稀释液面),振摇试管或换用1支1mL无菌吸管反复吹打使其混合均匀,制成1∶100的样品匀液。
制备10倍系列稀释样品匀液。每递增稀释1次,换用1支1mL无菌吸管或吸头。
2、接种和培养
选取3个适宜连续稀释度的样品匀液(液体样品可包括原液),接种于10mL LB1肉汤,每一稀释度接种3管,每管接种1mL(如果接种量需要超过1mL,则用双料LB1增菌液)于30℃±1℃培养24h±2h。每管各移取0.1mL,转种于10mL LB2增菌液内,于30℃±1℃培养24h±2h。如图1所示。

图1
用接种环从各管中移取1环,接种李斯特氏菌显色平板,36℃±1℃培养24h-48h。菌落形态应为蓝绿色菌落,带白色晕环,如图2所示。自每块平板上挑取5个典型菌落(5个以下全选)。
图2
3、结果判定
根据证实为单核细胞增生李斯特氏菌的阳性管数,查最可能数(MPN)检索表,报告每g (mL)单核细胞增生李斯特氏菌的MPN值。

在10-1-10-5五个连续稀释度中确定最适的三个连续稀释度方法如下:
a)有一个以上的稀释度3管均为阳性。选择三管都是阳性结果的最高稀释度及其相连的两个更高稀释度(见示例a、b,表中带下划线的数字对应的接种样品量为最终选取的最适稀释度,下同);

b)在未选择的较高稀释度中还有阳性结果时,则顺次下移到下一个更高三个连续稀释度(见示例c);
![]()
如果中间有某个稀释度没有阳性结果,但更高稀释度有阳性结果,则将此阳性结果加到前一稀释度,进而确定三个连续稀释度(见示例d);
![]()
如果不能按照这个原则找到三个合适的稀释度,则选择前一个较低的稀释度(见表示例e);
![]()
c)没有任何一个稀释度3管均为阳性。如果没有一个稀释度的3管均为阳性,则选择三个最低稀释度(见示例f);
![]()
如果在更高的没有被选择的稀释度还有阳性结果,将此阳性结果加到选择的最高稀释度,进而确定三个连续稀释度(见示例g)。
![]()
举例说明:若单核细胞增生李斯特氏菌的阳性管数的示例为3-3-2-0-1,则选择的稀释度为3-2-1,根据MPN检索表所得样品中含有单核细胞增生李斯特氏菌为1500CFU/g(mL)。

(二)平板计数法

1、平板计数
样品均质,如MPN法均质,所用均质的稀释液为BPW或LB。
选取2个-3个适宜的连续稀释度,每个稀释度的样品匀液分别吸取1mL以0.3mL、0.3mL、0.4mL的接种量分别加入3块李斯特氏菌显色平板上。倒置于培养箱,36℃±1℃培养24h-48h。菌落形态应为蓝绿色菌落,带白色晕环。如图3所示。
图3
选择有典型单核细胞增生李斯特氏菌菌落的平板,且同一稀释度3个平板所有菌落数合计在15CFU-150CFU之间的平板,计数典型菌落数。分以下6种情况:
①只有一个稀释度的平板菌落数在15CFU-150CFU之间且有典型菌落,计数该稀释度平板上的典型菌落;
②所有稀释度的平板菌落数均小于15CFU且有典型菌落,应计数最低稀释度平板上的典型菌落;
③某一稀释度的平板菌落数大于150CFU且有典型菌落,但下一稀释度平板上没有典型菌落,应计数该稀释度平板上的典型菌落;
④所有稀释度的平板菌落数大于150CFU且有典型菌落,应计数最高稀释度平板上的典型菌落;
⑤所有稀释度的平板菌落数均不在15CFU-150CFU之间且有典型菌落,其中一部分小于15CFU或大于150CFU时,应计数最接近15CFU或150CFU的稀释度平板上的典型菌落;
⑥2个连续稀释度的平板菌落数均在15CFU-150CFU之间按照公式二计算。
2、结果计算
公式一:T=AB/Cd
注:T:样品中单核细胞增生李斯特氏菌菌落。A:某一稀释度典型菌落的总数。B:某一稀释度确证为单核细胞增生李斯特氏菌的菌落数。C:某一稀释度用于单核细胞增生李斯特氏菌确证试验的菌落数。d:稀释因子。
例如,稀释100倍之后,三个平板典型菌落为80个,取5个典型菌落做鉴定,3个为阳性菌。
公式一计算:T=80×3/(5×10-2)=4800CFU/g(mL)
公式二:T=(A1B1/C1+A2B2/C2)/1.1d
注:T:样品中单核细胞增生李斯特氏菌菌落。A1:低稀释度典型菌落的总数。B1:低稀释度确证为单核细胞增生李斯特氏菌的菌落数。C1:低稀释度用于单核细胞增生李斯特氏菌确证试验的菌落数。A2:高稀释度典型菌落的总数。B2:高稀释度确证为单核细胞增生李斯特氏菌的菌落数。C2:高稀释度用于单核细胞增生李斯特氏菌确证试验的菌落数。d:稀释因子(低稀释梯度)。
例如,稀释10倍之后,三个平板典型菌落为80个,取5个典型菌落均做鉴定,3个为阳性菌。稀释100倍之后,三个平板典型菌落为10个,取5个典型菌落做鉴定,2个为阳性菌。
公式二计算:T=(80×3/5+10×2/5)/(1.1×10-1)=473CFU/g(mL)
3、结果报告
报告每g(mL)样品中单核细胞增生李斯特氏菌菌数,以CFU/g(mL)表示;如T值为0,则以小于1乘以最低稀释倍数报告。
注:本文属海博生物原创,未经允许不得转载。
上一篇:肺炎克雷伯氏菌检验



